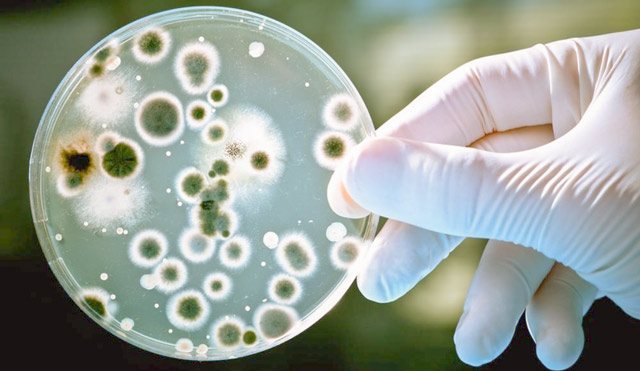
image

Здравствуйте, уважаемые читатели блога «Медицина и здоровье». Сегодня поговорим о том, как грибок поселяется в ухо человека, принося немало неудобств и страданий. Итак, новая тема — Отомикоз уха — грибок ушей, фото, симптомы, лечение, профилактика.
При упоминании о грибковых заболеваниях большинству людей наверняка вспомнятся грибок ногтей и молочница. Но, оказывается, есть такие грибы, которые растут в ушах, доставляя человеку массу неприятностей.
Так что ухо чешется не только к холоду или теплу, но и к отомикозу — грибковому заболеванию наружного и среднего уха, которое поражает наружный слуховой проход, барабанную перепонку и послеоперационные полости. Чаще всего отомикоз уха проявляет себя на фоне снижения иммунитета и изменения состава микрофлоры кожи.
Причины появления грибка в ухе
Микоз ушей вызван грибками, которые в норме присутствуют на кожных покровах. Такая флора называется сапрофитной. Сапрофиты не представляют опасности для здоровья до тех пор, пока не возникнут состояния, способные привести к их патогенности.
Такая ситуация возможна в следующих случаях:
- снижение иммунной защиты;
- онкологические болезни;
- повышенная потливость;
- СПИД;
- продолжительное лечение антибактериальными средствами и гормонами;
- аллергические реакции;
- дерматиты в области уха;
- стрессы;
- экзостозы, узкий слуховой проход;
- частые промывания слухового прохода;
- ушной дисбактериоз;
- травмы уха;
- инородные тела в слуховом проходе;
- сахарный диабет;
- несоблюдение гигиены;
- пользование чужими наушниками, берушами.
У больных в отделяемом уха при отомикозе чаще находят такие грибки:
- Niger.
- Fumigatus.
- Terreus.
- Flavus.
- Candida.
- Penicillium.
- Rhisopus.
Народный метод по удалению ушной пробки
- Растопить пчелиный воск в ненужной небольшой кастрюле.
- Приготовить 2-3 полоски хлопчатобумажной ткани, размером 5 см шириной и длиной 15 см.
- Опускать полоски ткани в горячий воск и накручивать пропитанную воском часть ткани на простой карандаш, создавая трубку из восковой ткани с одним расширенным концом.
- Лечь на бок, поставив узкий конец восковой трубки в ушную полость.
- Свободный расширенный конец трубки нужно поджечь и держать горящую с одной стороны трубку в ухе.
- После того, как половина восковой трубки перегорит, можно ее затушить.
Если интересно, какое количество ушной серы скопилось в ухе – размотайте трубку. Вытянутая из уха сера будет похожа на труху или комки грязи.
При наличии эндокринных заболеваний необходимо направить усилия на укрепление иммунной системы.
Классификация
Отомикоз уха делится в зависимости от вида возбудителя и от локализации патологического процесса.
По форме ушной микоз делят на:
- Криптококкоз.
- Кандидоз.
- Кокцидиоидоз.
- Бластомикоз.
- Аспергиллез.
- Мукоидоз.
По локализации заболевание подразделяют на:
- наружный (наблюдается в 50% от всех отомикозов);
- средний (развивается в 20% случаев);
- мирингит;
- отомикоз послеоперационной полости.
Микотическое поражение уха классифицируют и по стадиям патологического процесса. В стадии предвестников больного беспокоит постоянный зуд и заложенность в ухе. При этом внешне никаких изменений нет. В остром периоде патологии возникают боль, покраснение, отек, появляется ушное отделяемое. В хронической стадии заболевания симптоматика выражена слабее, характерны рецидивы и ремиссии.
Грибковое поражение уха
Отомикоз или грибковый отит, как его еще называют, является инфекционным заболеванием, поражающим внешнюю часть ушей. Причиной заболевания может стать или занесение штамма грибка или длительный прием антибактериальных препаратов местного назначения.
Наиболее подверженной группой людей считаются больные диабетом, дети и лица с нарушением иммунной системы. Отомикоз уха часто встречается в детском возрасте при ослаблении иммунитета.
Развитие заболевания происходит по нескольким причинам:
- изменение среды;
- травмы слухового прохода;
- попадание в ушной проём грибковой инфекции.
Ушная кислая среда может изменяться под воздействием попадания пыли, воды, или при жарком климате. Недостаток или избыток ушной серы может спровоцировать рост бактерий или размножение грибкового штамма. Количество ушной серы зависит от анатомического строения уха и использования ушных палочек для очищения ушной раковины от секрета.
Регулярное использование ушных палочек может привести к систематическому раздражению уха, при этом находящийся в нем секрет, утрамбовываясь, закрывает ушной канал. Это способствует риску образования ушной пробки.
Манипуляции, направленные на поддержание гигиены, способствуют гиперсекреции – увеличению количества ушного секрета. Избыток серы, кроме образования пробки, приводит к росту бактерий, населяющих ушную полость. Попадание грибковой инфекции при этом вызовет немедленное инфицирование, отомикоз наружной части уха.
Отомикоз по МКБ 10 имеет следующий код:
- В44.8+ – заболевание, вызванное грибками рода Аспергилл;
- В37.2+ – заболевание, вызванное грибками рода Кандида.
Симптомы отомикоза
Характерных признаков для рассматриваемой патологии нет. Симптомы отомикоза разнятся в зависимости от локализации патологического процесса, степени тяжести и возбудителя.
Наружный отомикоз
При наружном микозе уха признаки болезни возникают постепенно. Повышенная влажность, травмирование кожи слухового прохода, доступ кислорода ведут к уменьшению или полному исчезновению жировой пленки. Эти факторы способствуют отечности и закупориванию протоков желез, расположенных в коже. Через некоторое время больной начинает ощущать заложенность в ухе и зуд.
Кожа в слуховом проходе шелушится. Человек старается очистить ушную раковину, что еще больше повреждает кожные покровы, позволяя грибкам проникнуть в травмированный участок. Развивается острый процесс. Последний характеризуется болезненностью, гиперемией, обильным отделяемым, отеком. При тяжело протекающем процессе отечность достигает таких размеров, что закрывает слуховой проход полностью. Позже присоединяется шум в ухе и снижение слуха.
При наружном отомикозе отмечается воспаление лимфоузлов, височно-нижнечелюстного сустава, околоушной железы. При наличии у больного сопутствующих патологий или иммунодефицита инфекционный процесс переходит в среднее ухо.
Средний отомикоз
Симптомы среднего отомикоза уха появляются на фоне гнойного среднего отита. Больной жалуется на локализованную болезненность, ощущение заложенности в слуховом проходе, обильное выделение из него, шум.
Кроме этого, отмечается головная боль, имеющая односторонний характер, формирование ушных пробок. Для отделяемого из уха при среднем отите микозной этиологии характерен серый, зеленый, грязно-желтый или коричневый цвет. Запах отсутствует.
Если средний отомикоз вызван плесневыми грибками, то у больного повышается температура, отмечается ломота в мышцах, суставах. Возможны аллергические высыпания на коже.
Грибковый мирингит
Грибковый мирингит — воспаление барабанной перепонки, вызванное грибковой флорой. Вследствие патологического процесса подвижность перепонки снижается, и больной теряет слух.
Пациент жалуется на распирающее ощущение в ухе, болезненность, чувство инородного тела и отделяемое в большом количестве. На начальных этапах заболевания эти признаки неярко выражены. По мере развития патологии симптоматика усиливается. Болезнь протекает с периодами ремиссии и обострения.
Отомикоз послеоперационной полости
Отомикоз послеоперационной полости возникает при мастоидэктомии (удаление ячеек сосцевидного отростка). Болезнь характеризуется большим количеством отделяемого и болезненностью в заушной зоне.
Причины возникновения отомикоза
Отомикоз уха могут спровоцировать такие сопутствующие заболевания, как атопический дерматит, дерматозы, сопровождающиеся зудом (аллергический контактный дерматит, экзема, почесуха).
Во время расчесывания отдельных участков кожи грибки-сапрофиты, в нормальных условиях бессимптомно располагающиеся на поверхности эпидермиса, попадают в слуховой проход.
Отомикоз уха может развиться на фоне общих заболеваний, таких как:
- сахарный диабет;
- бронхиальная астма;
- туберкулез;
- заболевания кроветворной системы;
- злокачественные новообразования;
- ВИЧ-инфекция);
- местный дисбактериоз после наружного, острого и хронического гнойного среднего отита.
Заболеть можно после посещения бассейна, бани или сауны, примерки чужого головного убора, использования чужих наушников, травмирования ушного прохода различными посторонними предметами, включая ватные палочки и слуховой аппарат.
Если в ухе есть маленькая незаметная ранка или трещинка, то сохраняется и предрасположенность к появлению воспаления. Отомикоз уха часто диагностируется у людей определенных профессий: работников пунктов приема утильсырья, гардеробщиков.
Наружный слуховой проход — идеальное место для жизнедеятельности грибов. Повышенная влажность, постоянная температура, свободный доступ воздуха, отсутствие действия солнечных лучей, губительно влияющих на развитие грибов, обеспечивают благоприятные условия для микозов.
Оптимальная температура для подавляющего числа грибов — от плюс 25 °С. В нормальном состоянии организм легко справляется с их небольшим количеством. Но стоит снизиться защитным силам, и вы становитесь мишенью недуга, при котором происходит мгновенный рост колоний грибков.
Диагностика
Поставить диагноз при отомикозе помогают следующие методы:
- микроскопический;
- отоскопичекий и микроотоскопический;
- культуральный.
На отоскопии наружный микоз уха можно определить по суженому слуховому проходу, отечности, гиперемии, обильному отделяемому. При мирингите на барабанной перепонке скапливается мицелий грибка, световой рефлекс исчезает, перепонка отечна, характерно покраснение. Средний микоз уха проявляется перфорацией барабанной перепонки, сквозь которую проходит отделяемое.
Ушное отделяемое подлежит микроскопии. При отомикозе в нем обнаруживается мицелий и грибковые споры. Этим методом можно определить, к какому роду принадлежит возбудитель.
Бактериологический метод заключается в выращивании грибка на специальных средах. Это позволяет подсчитать количество колоний, сделать посев на чувствительность к лекарственным препаратам, идентифицировать вид.
При выявлении отомикоза обязательным исследованием является диагностика слуха. Она включает в себя аудиометрию, отоакустическую эмиссию, импедансометрию, обследование с камертоном.
Диагностика отомикоза
Зачастую пациенты обращаются за помощью к оториноларингологу именно с просьбой помочь избавиться от него. Несколько сложнее определить грибы Candida. По внешнему виду воспаление похоже на мокнущую экзему. Поэтому для постановки точного диагноза врач прибегает к забору посева.
Наличие отомикоза можно попытаться определить в домашних условиях. Для этого ватную турунду аккуратно вставьте в ухо, повращайте… Если на ней будет заметен похожий на порошок темный налет или видна творожистая масса серого цвета, то можно говорить о наличии ушного грибка. Однако лучше диагностику доверить опытному отоларингологу.
Отомикоз уха называют еще дисбактериозом органа слуха, ведь развивается он при нарушении кислотно-щелочного баланса микрофлоры. Коварство грибка заключается в том, что он напоминает ушной отит, поэтому пациенты, занимаясь самолечением, усугубляют ситуацию.
Лечение отомикоза
Первым делом необходимо выявить причину, приведшую к развитию болезни, и устранить ее:
- прекратить принимать антибактериальные средства;
- повысить устойчивость организма к инфекциям;
- принимать витаминные препараты;
- при аллергических реакциях принимать антигистаминные средства.
Способы устранения причины отомикоза необходимо обсудить с лечащим врачом. Лечиться самостоятельно категорически запрещено.
Лечение отомикоза уха препаратами может дополняться упражнениями, диетой с включением в рацион овощей и фруктов, здоровым отдыхом, народными средствами.
Лечение отомикоза препаратами должно включать назначение антимикотиков (местно и внутрь), промывание ушей, иммунокоррекцию, витаминотерапию, десенсибилизирующее лечение.
Медикаментозная терапия зависит от вида возбудителя, тяжести течения болезни и сопутствующих патологий:
- промывать уши можно средствами с Нистатином, Амфотерицином, Клотримазолом;
- лечить отомикоз, вызванный плесневыми грибками, необходимо такими препаратами, как Нитрофунгин, Атраконазол, Тербинафил;
- Флуканазол при отомикозе эффективен в отношении дрожжеподобных грибков. Подобным действием обладают Пимафуцин, Эконазол и Клотримазол. Данные препараты можно приобрести в виде раствора. В одной из этих жидкостей смачивают жгутик, который помещают в пораженное ухо;
- устранить наружный отомикоз поможет Кандибиотик. Помимо уничтожения грибка, данный препарат предназначен для уменьшения воспалительного процесса;
- для местного нанесения подойдет Ламизил, Экзодерил и Кандид Б в виде мазей;
- при отсутствии эффекта от вышеперечисленного лечения противогрибковые препараты назначают внутрь. В виде таблеток выпускаются Флюкостат и Пимафуцин;
- если антимикотические препараты пришлось принимать внутрь, то они могут пагубно влиять на кишечную микрофлору. Поэтому совместно с ними назначают Линекс, Бифиформ или Аципол;
- повысить местный иммунитет помогут ушные свечи Виферон. Для усиления общих защитных сил организма внутрь можно принимать Иммунал, Имунорикс. Полезен и прием витаминов;
- для десенсибилизации могут быть назначены Цетрин, Тавегил.
Перед местным применением лекарственного средства нужно очистить ушную полость водой или глицерином. Это обеспечит лучшее проникновение препарата.
Отзыв: Ушные капли «Кандибиотик» Glenmark Pharmaceuticals. Как я избавилась от отомикоза уха
Недостатки: Не отмечены
Пять месяцев назад мне выставили диагноз — отомикоз уха. Мне казалось, что это была простуда, поскольку кроме боли в ухе были еще катаральные явления. Боль была терпимой, но заложенное ухо ничего не слышало. До обращения к врачу я занималась самолечением, которое ничего не дало.
Врач уточнил диагноз, промыл слуховой проход и назначил капли кандибиотика с нитрофунгином.
Кандибиотик согласно описанию состоит из клотримазола (противогрибковое средство) и хлорамфеникола (антибиотик с широким спектром действия).
Показания:
- отит наружного уха острый, либо диффузный
- острая форма среднего отита
- хроническая стадия отита при обострении
- состояние после проведенной хирургической операции на ухе.
Казалось, причем здесь отомикоз уха, о котором ничего не сказано в аннотации. Однако все дело в активном компоненте препарата, играющим существенную роль в лечении грибка уха.
Курс лечения пять дней
День 1-й
Утром закапала перекись водорода в ухо, жду пока пошипит, затем капаю кандибиотик
Вечером капаю кандибиотик и нитрофунгин
Второй и последующие дни все так же, но без использования перекиси водорода.
Кандибиотик представляет собой масляную, жирную массу. Препарат не обладает согревающим эффектом, не вызывает щекотку или зуд. К сожалению, хотя я лежала несколько минут на диване, после жидкость все равно вытекала из уха, загрязняя волосы. Но это не беда.
Кандибиотик имеет пипетку, точно дозирующую количество капель. Могу всех обрадовать. На 3-й день ухо стало слышать, исчезла заложенность. На мой взгляд первичная обработка уха у ЛОР-врача сыграла важную роль в удалении грибка.
После пятидневного курса лечения явилась на осмотр. Врач констатировал полное излечение отомикоза уха. Но для профилактики рекомендовал прокапать препараты еще три дня.
Если у вас выявили отомикоз уха, пройдите такой же курс лечения, согласовав со своим лечащим врачом. Будьте здоровы!
Лечение отомикоза народными средствами
Народные средства против отомикоза могут использоваться только в комплексе с медикаментозной терапией. Известны следующие народные рецепты для устранения отомикоза:
- измельчить 1 луковицу, отжать сок. Перед сном закапать в ухо 5 капель сока. Проделывать процедуру не меньше трех дней;
- устранить симптоматику болезни способен отвар или сок чистотела;
- смешать яблочный уксус и воду в соотношении 2:1. Намочить полученным раствором жгутик и поместить его в наружный слуховой проход;
- ежедневно следует высушивать ухо феном. Это устранит влажность, которая необходима для размножения грибковой флоры.
Общие сведения
Отомикоз – в переводе с латыни «ушной грибок».
Это заразное инфекционное заболевание наружного слухового хода, которые провоцируется несколькими возбудителями:
- Candida;
- Rhisopus;
- Penicillium;
- A. flavus;
- A. fumigates;
- A. terreus;
- A. niger.
Согласно статистическим данным, болезнь поражает как детей (около 27%), так и взрослых (18%). В группе риска – жители регионов с жарким влажным тропическим климатом, люди среднего возраста, в частности те, кто занимается плаванием, носит слуховые аппараты, наушники. Также в большей степени подвержены заражению люди, перенесшие мастоидотомию.
Важно! В 90% случаев отомикоз носит односторонний характер, то есть поражает только одно ухо.
Последствия
Лечение отомикоза необходимо начинать как можно раньше. В противном случае патология ведет к тяжелым последствиям.
Острый процесс может перейти в хроническую форму с периодическими обострениями. В этом случае возрастает вероятность развития экземы наружного слухового прохода.
Микоз уха может способствовать присоединению возбудителей бактериальной инфекции.
В случае локализации процесса в среднем ухе возможно необратимое снижение слуха.
При неправильной или несвоевременной терапии, а также в случае тяжелого течения процесса, грибки могут проникать в кровь и распространяться по всему организму.
Симптомы
Симптоматика инфекционного отита, вызванного грибковой инфекцией, включает:
- ощущение заложенности уха;
- чувство распирания и ощущение нахождения инородного тела;
- отечность поражённой стороны;
- ухудшение слуха;
- боль;
- покраснение;
- зуд;
- сужение слухового прохода;
- выделения из ушной полости гнойного экссудата.
Эти симптомы указывают на развитие острой формы отита.
Хроническая форма при отомикозе может развиться из запущенного состояния болезни, вызванного неадекватным лечением или незавершенной терапией. Хроническая форма характеризуется длительным протеканием заболевания – до 4 недель, при этом, обострение заболевания проходит ежесезонно.
Как и при других инфекционных или воспалительных заболеваниях, проходит без острой симптоматики. Симптомы острой инфекции при этом протекают вяло, без острых болей и обильных выделений.
Распространено заболевание при постоянном контакте с водой, у жителей жаркого климата, при чрезмерной гигиене ушной полости.
Профилактика ушного грибка
Пациентам, излечившим отомикоз, следует уделять особое внимание профилактике, так как эта болезнь способна часто рецидивировать. К профилактическим мерам относятся:
- лечение сопутствующих заболеваний;
- закаливание;
- правильный прием антибиотиков и гормональных средств;
- тщательное высушивание ушей после купания, приема душа;
- правильная гигиена ушей;
- предупреждение травмирования кожных покровов, воспалительных заболеваний;
- общеукрепляющие мероприятия;
- периодическое смазывание слуховых ходов противогрибковыми средствами;
- правильное питание;
- не использовать ватные палочки для чистки ушей: это дополнительный фактор риска травмирования кожи.
Отомикоз — заболевание, которое может приобрести хронический характер и привести к тяжелым последствиям. Зачастую микоз уха носит рецидивирующее течение.
Однако своевременная диагностика, лечение сопутствующих патологий, применение антимикотических препаратов способны заставить болезнь отступить надолго. Профилактические мероприятия в дальнейшем, соблюдение всех рекомендаций врача помогут избежать нового развития отомикоза.
Нет похожих статей.
Профилактика
Профилактические меры, применяемые для предупреждения рецидива или первичного заболевания, должны быть направлены на укрепление иммунной системы, поддержания личной гигиены.
Профилактика отомикоза:
- соблюдение гигиены ушной полости;
- своевременное лечение эндокринных, воспалительных заболеваний;
- избегать регулярного попадания воды в ушную полость;
- после принятия ванны или душа необходимо дать высохнуть ушной полости естественным путем, не применяя для этого ушные палочки;
- не пользоваться предметами гигиены постороннего человека, не носить чужие головные уборы;
- на отдыхе в жарком климате следить за гигиеной рук, не касаться ними ушных раковин, чтобы предотвратить инфекционное заражение.
Избавиться от причин вызывающих грибковое поражение можно, выполняя гигиену ушной полости, предотвращая местный дисбактериоз. Нарушенный баланс среды или количества серы способствует заражению, развитию заболевания.
При большом скоплении серы необходимо посетить отоларинголога для процедуры по удалению ушной пробки, симптомами разростания которой является:
- ухудшение слуха;
- частый звон в ушах.
Эффективные лекарства
Большинство препаратом из группы антимикотиков имеют широкий спектр воздействия и поэтому применять их можно при любом типе возбудителя. Наиболее эффективными считаются следующие препараты:
- «Нистатин».
- «Экзодерил».
- «Клотримазол».
- «Ламизил».
- «Дифлюкан».
- «Кандибиотик».
- «Эконазол».
- «Интраконазол».
- «Дексона».
- «Тербинафин».
Схема применения того или иного лекарства от грибкового отита определяется только специалистом.

Виды микотического отита
Принимая во внимание то, где именно развивается грибок, отит делится на следующие виды:
- Наружный отит. Инфекция затрагивает внешнюю часть уха и наружный проход. При этом появляются следующие симптомы: заложенность, шелушение кожи, отечность наружного уха. В острой фазе отмечается сильная боль и выделения из ушей. Чаще всего при патологии воспалены околушные железы и лимфоузлы;
- Грибковый мирингит. Самый редкий вид отита. Грибки поражают барабанную перепонку. При этом существенно снижается слух, появляется сильная боль, а также обильные выделения;
- Средний отит. Грибок, который распространился из слухового прохода, размножается в среднем ухе. Признаки воспаления становятся более заметными, появляются головные боли, скопление серных пробок, выделения из уха. При заражении плесневелыми грибами может появиться гипертермия, озноб, ломота в суставах;
- Послеоперационный отит среднего уха. Заболевание развивается в среднем ухе из-за снижения местного иммунитета после проведения операции.
Чего надо бояться при отомикозе?
Грибковый наружный отит имеет склонность к хронизации процесса, формированию вялотекущего, постоянно персистирующего процесса грибкового воспаления. При этом усиление симптоматики провоцируется либо приемом антибиотикотерапии или изменениями в диете: обилием «быстрых» сахаров – когда грибы начинают расти «как на дрожжах».
Длительно протекающие грибковый процесс приводит к сенсибилизации (аллергизации) организма, снижению иммунитета, а наличие зуда часто приводит к появлению расчесов и опасности вторичного гнойного инфицирования.
Возможные осложнения
При неправильно подобранном консервативном лечении в домашних условиях врачи не исключают резкое ухудшение общего самочувствия пациента любого возраста. Опасаться стоит возможных симптомов сепсиса, не исключена резкая потеря остроты слуха. Постепенное разрушение барабанной перепонки может стоить пациенту инвалидности по причине развития глухоты.
Главной проблемой при остром процессе является перфорация барабанной перепонки. В этом случае, после стихания заболевания формируются спайки, которые тянут слуховую перепонку. Это провоцирует шум в ушах и головные боли.
После разрешения острого воспаления, процесс может принимать характер хронического. А при длительном течении такого воспаления происходит снижение слуха, вплоть до полной его потери. Поэтому не стоит тянуть с походом к врачу.
Методы лечения

Так как недуг зачастую получает свое развитие на фоне ослабленной иммунной защиты, то возникает необходимость в выяснении причин, приводящих к этому. Свое особое воздействие на организм могли оказать стероидные препараты от отомикоза, длительный прием антибиотиков, недостаточно сбалансированное питание, сопутствующие заболевания и другие факторы. Поэтому прием витаминов, правильный рацион питания, исключение провоцирующих препаратов было бы целесообразным в данный период.
Грибковый отит у человека – это не только физические неудобства, но психологический дискомфорт, который может выражаться в пониженной слуховой способности. Поэтому лечение отомикоза необходимо на ранних периодах, сразу после возникновения первых симптомов недуга. Ведь в запущенных состояниях отомикоз может получить распространение на внутренние органы и стать причиной грибкового сепсиса.
Лечение наружного грибкового отита можно начинать с применения антимикотических средств. Предварительно проводятся гигиенические мероприятия в виде промывания ушного прохода для очищения от разных выделений в виде слущенного эпидермиса, мицелия грибков, серы.
Назначение антибактериальных средств оправдано при отомикозе наличием смешанной микрофлоры. В лечение грибкового отита могут включать, в качестве дополнительной терапии — применение антибактериальных средств. Использование народных средств, при несложном протекании отита допускается лишь при диагностике легких форм недуга и с разрешения лечащего врача. Хотя процесс лечения может быть сложным и затяжным, фактор успешности выздоровления во многом зависит от правильно поставленного диагноза и своевременно начатого эффективного лечения.
Лабораторная диагностика
После физикального осмотра уже можно поставить диагноз «отомикоз», но он останется под вопросом до проведения микроскопических лабораторных исследований. В некоторых случаях результаты однократного проведения такого анализа могут не показать наличие грибкового поражение, тогда стоит провести ретест патологического отделяемого.
Для получения образцов патологического отделяемого используют ложку Фолькмана или аттиковый зонд. При помощи данных инструментов биологический материал собирается из глубоких отделов наружного слухового прохода. Микроскопические исследования являются самыми информативными и достоверными при постановке данного диагноза.
Дифференциальную диагностику грибкового отита стоит проводить для правильного выбора тактики лечения, чтобы отличить отомикоз от аллергического отита, бактериального отита, новообразований уха, экземы и других воспалительных процессов наружного слухового прохода и внутреннего уха.
Диагностические мероприятия
Когда развивается отомикоз, диагностика заключается в проведении культурального и микроскопического исследования. Для этого необходимо провести забор содержимого, которое отделяется из полости ушного канала.
Данную процедуру необходимо проводить грамотно. Материал должен быть взят в достаточном количестве и только из очага поражения. В противном случае обнаружить грибковые споры затруднительно.
Для постановки такого диагноза доктором проводится визуальный осмотр, во время которого определяется покраснение эпителиального слоя, гиперемированность слизистой, наличие патологического содержимого. Определить наличие отомикоза среднего ушного отдела возможно при проведении отоскопии.
При ее проведении обнаруживается прорыв барабанной перепонки, а также присутствие патологического содержимого.
При наличии грибкового менингита обнаруживается гиперемированная, отечная барабанная перепонка. На ее поверхности визуализируются грибковые споры, а также полное отсутствие светового рефлекса. Как лечить данное заболевание, должен определять только квалифицированный специалист.
Возбудители грибковой инфекции
Возбудителями отомикоза является грибковая флора сапрофитного характера. Обычно грибки спокойно обитают в разных зонах человеческого тела и до поры до времени не проявляют никаких вирулентных признаков.
Диагноз «отомикоз» устанавливается в соответствии с полученными сведениями микроскопического изучения отделяемого из ушного прохода и результатами бакпосева на присутствие грибков:
- Обычно в мазках из ушей человека выявляется Aspergillus niger.
- В местности с континентальным климатом в отделяемом из ушного прохода находят грибки Candida.
- Для тропиков возбудителями болезни являются плесневые грибы из рода Aspergillus. Отомикоз также вызывается дерматофитами или актиномицетами.
Что будет, если не лечить отомикоз?
Основным признаком неблагоприятного течения грибкового поражения уха или неэффективности лечения является увеличение региональных лимфоузлов, которое свидетельствует о наличии выраженного инфекционного процесса.
Этиология
Отомикоз вызывают сапрофитные грибы — нормальные обитатели тела человека:
- Дрожжеподобные грибы рода Candida,
- Плесневые грибки рода Aspergillus, Penicillium,
- Актиномицеты,
- Дерматофиты.
Факторы, способствующие развитию отомикоза:
- Травматическое поражение ушей,
- Гипергидроз,
- Несоблюдение гигиены ушей,
- Экзостозы и узость слухового прохода,
- Дерматиты различной этиологии, проявляющиеся зудом ушной раковины,
- Дисбактериоз уха,
- Воспалительные заболевания ушей,
- Длительная антибиотикотерапия и гормонотерапия,
- Частые промывания ушей,
- Сахарный диабет,
- СПИД,
- Аллергия,
- Онкозаболевания,
- Ослабленный иммунитет,
- Стрессы,
- Использование чужих берушей, наушников, гарнитуры.
Причины развития болезни
Основной возбудитель отомикоза уха – это грибковая инфекция. Она распространяется в теплом климате, но некоторые грибки могут попасть в организм, если есть кандидоз кожи либо генитальный кандидоз. Ещё эту болезнь могут стимулировать дерматофиты либо актиномицеты.
В некоторых случаях отомикоз появляется вследствие травмы уха или попадания внутрь инородного тела. Повлиять на развитие болезни может излишнее потоотделение или мелкие царапины при почёсывании. Нарушение правил гигиены также может спровоцировать недуг.
Ещё одной причиной болезни может стать дисбактериоз. Если человек болел, к примеру, отитами, и делались специфические процедуры (промывания, приём антибиотиков), это может привести к отомикозу наружного или среднего уха. Также болезнь может вызвать ослабление иммунной системы, аллергия или диабет.
Лечение
Заболевание характеризуется рецидивами и нередко переходит в хроническую форму, поэтому лечение бывает длительным и непростым. В начале пациенту тщательно очищают больное ухо и наружный проход от скопившегося там мицелия. Вычищение проводится путём бережного извлечения всех гнойных масс.
После очистительной процедуры на коже порой остаются мельчайшие эрозии.
Оставшиеся в ушах выделения удаляют обыкновенным промыванием. Для такой цели используют 3% раствор перекиси водорода.
Для промывания ушей также можно брать жидкость Бурова, жидкость Кастеллани. После этой процедуры слуховой проход осушается. Далее используется противогрибковая мазь.
Каждый вид грибка требует определённого специализированного фунгицидного препарата:
- Например, для Candida подойдёт Нистатин.
- Aspergillus niger чувствителен к Нитрофунгину.
- Aspergillus glaucus лечится с помощью Лютенурина.


- Миконазол,
- Клотримазол,
- Микозолон.
Миконазол

Миконазол
Мазь прикладывают к воспалительному очагу 3 или 4 раза в сутки на тридцать минут. После применения лекарственного средства ухо обязательно очищают и промывают 3% раствором Перекиси водорода. Для очистки можно использовать Борную кислоту. Сразу после промывания рекомендуется в проход закапывать 3 капли 4% раствора Салициловой кислоты.
Использование мазей или гелей против грибка можно чередовать с иными средствами. Например, рекомендуется применять 10% раствор нитрата серебра. Им смазывают кожный покров возле больных ушей.
При рецидивных формах следует прибегнуть к общей терапии:
- Больному назначается Нистатин на протяжении 14 суток. Затем делают перерыв на семь дней и лечение опять возобновляют.
- В качестве общей десенсибилизирующей терапии назначают Диазолин, Димедрол, витаминные препараты.
Совет! Лечение отомикоза рекомендуется сопровождать мероприятиями, устраняющими провокационные факторы. В процессе терапии повышают иммунитет и нормализуют ушную микрофлору. Добиться положительного результата можно, если использовать витаминотерапию, общеукрепляющие средства, излечить фоновые заболевания и отменить антибиотики.
Капли «Кандибиотик»
Многокомпонентное лекарство в виде капель считается одним из эффективнейших при различных заболеваниях уха. Препарат помогает одновременно купировать болевой синдром, устранить неприятные ощущения и побороть развитие болезнетворных микроорганизмов, в том числе и грибков.
Антимикотическое действие капель обеспечивает вещество клотримазол, а антибактериальное – хлорамфеникол. В качестве анальгетика в состав препарата включен лидокаин. Выраженным противоаллергическим эффектом обладает беклометазон – еще один компонент капель «Кандибиотик».
Физикальная диагностика
При поражении пенициллиновыми грибами, процесс как правило локализируется в наружном слуховом проходе. Во время физикального обследования отмечают незначительную инфильтрацию кожи наружной части слухового прохода, что не приводит к полному закрытию его просвета. Визуализируется гиперемия барабанной перепонки, иногда она частично выпячивается, что создает ложные представления о её перфорации.
В ряде случаев дифференциация отомикоза при пенициллиозных поражениях является затруднительной по той причине, что патологическое отделяемое имеет различные оттенки серого цвета и очень напоминает ушную серу, в некоторых случаях появляются сухие корки или пленки. Такие «псевдо серные корки» покрывают практически всю поверхность слухового прохода.
В случае аспергиллезного отомикоза также сужается слуховой проход как следствие инфильтрации его кожи, но инфильтрация больше выражена в костном отделе. Практически все случаи такого вида отомикоза сопряжены с инфильтрацией барабанной перепонки. Иногда отмечается грануляция. Патологическое отделяемое при аспергиллеозных отомикозах имеет обильный характер и отличается по цвету от пенициллиозных. Обычно оно серых оттенков и имеет в примеси черные точки, может напоминать промокшую газету.
Кандидозному поражению слухового прохода присуща умеренная инфильтрация, более выраженная в хрящевом отделе, при отоскопии барабанная перепонка имеет гиперемированную поверхность. Патологическое отделяемое имеет творожную консистенцию белого цвета и оно более жидкое в сравнении с другими отомикозами. Часто происходит распространение процесса на кожу наружного уха.
Принцип борьбы с заболеванием
Самое главное, что необходимо сделать, начиная борьбу с грибком в ухе, – тщательно его почистить. Вы должны удалить с поверхности кожного покрова все патогенные микроорганизмы. Для этого можно использовать средства для промывания, повторять подобные процедуры нужно 7–10 раз в неделю.
Если вы не имеете такого опыта либо боитесь себе навредить, обратитесь за медицинской помощью к лечащему врачу. Если отомикоз сопровождается сильным болевым синдромом, необходимо применять анальгетики.
Самое главное при терапии грибка уха – это не повредить барабанную перепонку. Последствием такого нарушения станет дальнейшее распространение инфекции по среднему уху.
Как только прочистите ушную раковину и наружное ухо, приступайте к закапыванию. Для этого возьмите противогрибковые ушные капли, в запущенных случаях необходимо использовать таблетки. Кроме капель, вы можете обрабатывать ушной проход кремами и гелями. На начальных стадиях избавиться от грибка в ухе достаточно просто, однако подход к терапии должен быть комплексным. Лучше всего, чтобы лечение проходило под контролем врача. При длительном отсутствии терапии отомикоза грибок может распространиться на кости черепа – в таких случаях без госпитализации обойтись уже никак не получится.
Мазь и раствор «Экзодерил»
Выраженный противогрибковый эффект имеет препарат «Экзодерил», выпускаемый в форме мази и раствора для наружного применения. Основным действующим компонентом в состав лекарства является нафтифин – синтетическое противогрибковое вещество из группы аллиламинов.
Лечить грибковый отит можно как мазью, так и раствором «Экзодерил». Перед нанесением лекарства следует подготовить пораженную микробами поверхность. Необходимо учитывать, что на поврежденные кожные покровы препарат наносить нельзя. Средство может вызвать сухость и жжение. Количество нанесений мази или раствора, длительность терапии устанавливает только врач. После исчезновения симптомов грибковой инфекции применять антимикотический препарат следует еще в течение 7-14 дней.
Грибковый отит: лечение заболевания
Грибковая инфекция считается довольно опасным недугом, который следует лечить только под наблюдением врача. Местная терапия является основным методом воздействия на патологию. Пациентам показано применять антимикотические лекарственные средства, подобранные специалистом. Для усиления лечебного эффекта некоторым пациентам назначают общую противогрибковую терапию. При обнаружении отомикоза необходимо прекратить лечение антибиотиками, если пациент принимал их по каким-либо причинам.
Лекарства для поднятия иммунитета, витаминные комплексы также помогут справиться с таким недугом, как грибковый отит. Лечение заболевания у детей следует проводить только с помощью медикаментов, назначенных врачом. В противном случае существует огромная вероятность неполного излечения, что приводит к хроническому течению инфекции.
Для промывания ушных проходов используют антисептические растворы. Обрабатывать поверхность рекомендуется перед каждым нанесением местных противогрибковых препаратов.
Как и чем лечить недуг
При адекватной своевременной терапии и соблюдении пациентом всех процедур, в том числе гигиенических требований, успех гарантирован. Для лечения отомикоза назначаются препараты фунгицидного и фунгистатического (убивающего патогенную микрофлору и задерживающего ее развитие) действия.
Терапия отомикоза имеет приоритетное значение не только из-за широкого распространения данного заболевания, но и из-за более тяжелого течения, чем при других инфекционных болезнях ЛОР-органов. Недуг может стать причиной грибкового сепсиса, особенно у детей младшего возраста. Неблагоприятным моментом являются ранее проведенные хирургические вмешательства в полости уха.
При нетяжелых формах отомикоза лечение чаще всего проводят местно. Терапия включает в себя обязательную механическую очистку слухового прохода от серы, грибкового мицелия, слущенного эпителия кожи. Далее применяются различные капли в уши от грибка на основе анилиновых красителей, уксусной и борной кислоты, производных имидазола и др. Используют также вазелиновое и камфорное масло.
При наличии плесневого грибка доктор назначает нитрофунгин, итраконазол, нафтифин. Дрожжевой ушной грибок эффективно излечивается флуконазолом, пимафуцином, клотримазолом, экзодерилом и эконазолом. Препараты в виде мазей необходимо наносить на ватный диск и закладывать в ухо 4 раза в день. Лекарственные средства чаще всего назначаются по схеме пульс-терапии, то есть применение значительных доз препаратов в течение небольшого промежутка времени.
При терапии отомикоза успешно используются медикаменты-кандибиотики, созданные по принципу «три в одном»: обладающие противогрибковыми, антибактериальными и противовоспалительными свойствами.
Если терапия не приносит желаемого эффекта, доктор назначает таблетки, позволяющие облегчить состояние. Чтобы курс лечения не нанес вреда микрофлоре желудка и кишечнику, необходим прием «Хилак форте», гастофарма, бификола.
Варианты лечения грибка в ушах народными средствами в домашних условиях:
- закапывание сока чистотела несколько раз в день;
- луковый сок по 5 капель на ночь;
- яблочным уксусом разрешается только смазывание, закапывание запрещено;
- промывание перекисью водорода 4 раза за день.
Для более эффективного избавления от болезни специалисты рекомендуют разнообразить рацион фруктами и овощами, а также не забывать о приеме витаминов.
Возбудитель и пути передачи
Микроорганизмы проникают внутрь из-за систематического повреждения эпидермиса уха при удалении скопившейся ушной серы.
Как и любая инфекции, грибковый отит не возникает сам по себе. Чаще всего причиной всему становятся:
- микотическая атака плесневелых грибов рода аспергилла;
- разросшиеся дрожжевые кандидозные колонии;
- проникновение других редких штаммов.
Aspergillus — аэробный плесневелый гриб, который насчитывает более 200 разновидностей. Представляет собой мохнатые колонии, меняющие цвет в ходе развития. Они быстро растут на благоприятной среде и размножаются спорами. В результате жизнедеятельности выделяют много токсических веществ. Стойки к неблагоприятным внешним воздействиям.
Candida – дрожжеподобный представитель грибного царства. Характеризуется стремительной контагиозностью. В отличие от плесени не образует мицелий (корней), размножается клеточным делением высокотоксичен.
В организме человека с пониженным иммунитетом любые грибки способны паразитировать в кровотоке и внутренних органах, вызывая необратимые состояния.
Чрезвычайно вкусной для них является питательный секрет, образующийся вместо недостающей серы, от которой почему-то все основательно пытаются избавиться. Но не только этот факт провоцирует размножение. Близость кровеносных сосудов, теплое и постоянно увлажненное состояние ушей в какой-то степени тоже способствуют возникновение недуга.
Патогенные микроорганизмы при отомикозе передаются при:
- несоблюдении правил личной гигиены: купании в метах несанкционированных пляжей с неисследованной санитарной службой водой, недостаточности гигиенических процедур после купания;
- длительной антибиотикотерапии с употреблением ушных капель;
- облучении больных, лечащихся от злокачественных новообразований.